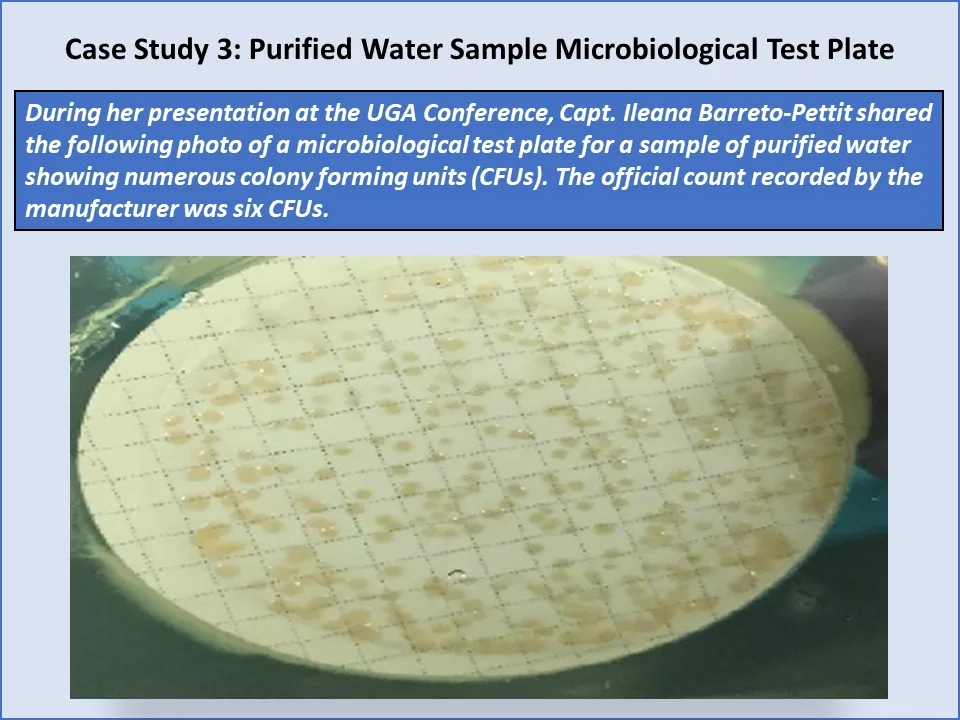
image 6
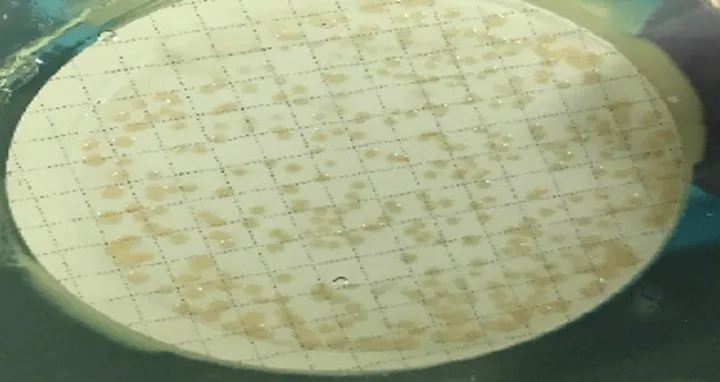
Microbiological Issues with Aseptic Processing and Lyophilization: CGMP Inspection Case Study by FDA National Drug Expert Ileana Barreto-Pettit

Table of contents
At the International GMP Conference at the University of Georgia in Athens, Georgia, in early March 2020 co-sponsored by FDA, FDA Office of Regulatory Affairs National Drug Expert Captain Ileana Barreto-Pettit presented FDA drug GMP warning letter trends over recent years and provided in-depth case studies from Current Good Manufacturing Practice (CGMP) inspections.
Barreto-Pettit has been with FDA for 21 years. She has been a drug investigator since 1999 and a Drug National Expert Investigator since 2017, and is a Captain in the US Public Health Service Commissioned Corps.
The CGMP inspection case studies Barreto-Pettit provided include an in-depth analysis of the findings, lessons learned, and how companies can avoid similar findings. Areas examined in the case studies are:
- Cleaning and cross-contamination issues with an encapsulator
- Inadequate media fills at a sterile manufacturer when starting up after a shutdown, and
- Microbiological issues at a large manufacturer of sterile injectable products produced by aseptic processing and lyophilization.
These are presented in a three-part series of blog posts (click here for Part 1, and here for Part 2).
[NOTE: Are you interested in learning more about observations filtered by FDA issue/Keyword “Aseptic Processing”? Get your FREE 483 Observation Report and you can quickly determine who has been hit with this observation and more. Learn more here.]

Part 3: Microbiological Issues with Aseptic Processing and Lyophilization
Ileana Barreto-Pettit relayed this GMP inspection case study as a story. Following are her complete remarks.
In this case—which was someone else’s case—a national expert investigator went on inspection with a microbiologist, who found a bag of used petri plates that had been read that day and were going to be disposed of.
The plates were examined and compared to what had been recorded. The interesting thing is that this company knew we were coming, because it is a foreign inspection. They get notified ahead of time, and issues like this still happen.
For every petri dish the microbiologist examined, the reading did not match what had been recorded. For example, for a purified water sample, how many CFUs (colony forming units) do you see (in the picture below)? The official report recorded six CFUs:
This was one of the worst ones, but many of them had between three and seven CFUs and reported zero. This happened with environmental monitoring plates as well as with purified water samples. The purified water is used for cleaning equipment. Obviously, their purified water system was not in control.
LOD (loss on drying) results for several batches of API and sterile drug product did not meet specification when tested during the inspection. The investigator in this case was a chemist who is familiar with this test. He used to work in an FDA laboratory. While investigating at this company, he found lyophilized products with a lot of defects. He also found that there were some OOS (out-of-specification) investigations for assay and impurities.
He looked at some retain samples and saw defects on batches that were released. He selected several API (active pharmaceutical ingredient) and finished product batches and asked the company to test them for loss on drying.
The investigator found that the only way to change the results was to alter the sample weights. That is what they were doing. The analysts were changing the sample weights to make the LOD result pass at release.
He was in the laboratory from 8:00 am until 10:30 pm because the samples take six hours each in the oven before testing. All the samples that had passed in months prior failed, with results as much as 50% different. There was an average 31% difference between release test results and re-test results during the inspection. These products—lyophilized antibiotics—should be stable. That is one of the reasons products are lyophilized. There should be no change. This variation was not expected at all, especially within a month.
In addition, he found that the analysts in the lab were not recording the drying time. Even though they were required to record it, it was not being recorded. So, there was no way of knowing how long the samples were in the oven before testing.
The investigator found that the only way to change the results was to alter the sample weights. That is what they were doing. The analysts were changing the sample weights to make the LOD result pass at release.
This is a global US company with facilities in foreign countries. This was a foreign plant of a big pharma company. How does this happen? It is beyond my understanding.
As a result, CAPAs were not implemented to address lyophilization issues leading to high defect rates. The company ended up recalling all batches distributed to the U.S. Even though this facility was foreign, 100% of their products went to the US.
At the same company he observed excessive critical drug quality defects, such as melt back and cake collapse in lyophilized product and in reserve samples. Company investigations did not identify root causes for high defect rates. Some were saying it was power failures and compressor tripping of the lyophilizer that disrupted the lyophilization cycle leading to insufficient and non-uniform water removal, leading to failures in assay, impurities, and water content. They were blaming it on equipment.
However, there were some lots that did not have power failures that also had critical defects. The Quality Unit did not detect the adverse signals of excessive defects and major manufacturing deviations to re-assess process design and controls. As a result, CAPAs (corrective actions and preventive actions) were not implemented to address lyophilization issues leading to high defect rates. The company ended up recalling all batches distributed to the U.S. Even though this facility was foreign, 100% of their products went to the US.
The Consequences
Once you have this kind of data integrity issue in more than one place, what can be trusted? The company tested all the batches that were on the market, and they were sub-potent because their moisture content was too high, and the product was degrading. So, they were not meeting purity and they were sub-potent. Some were penicillin products.
In addition to recalling all the products, the company was placed on import alert, meaning that we will not allow any products coming from that facility into the US. The warning letter required the company to perform comprehensive investigations into the extent of the inaccuracies in data, records, and reporting, as well as a current risk assessment of the potential effects of these observed failures on the quality of the drugs.
Finally, it required a management strategy that includes a global corrective and preventive action plan. Remember, this company has facilities around the globe. We are requiring it to address not just the facility where the issues were found, but globally. We had better not find the same problems at a plant run by the same company in a different country.
Avoid Making the Same Mistakes
Does your Quality Unit…
- Have controls to prevent data integrity issues in manufacturing and control laboratories (micro and analytical)?
- Have a system to detect discrepancies in data integrity? How do you know it works?
- Conduct effective internal audits to identify practices that are not in conformance with cGMPs?
- Monitor adverse signals to identify quality issues in a timely manner and implement corrective and preventive action?
It should not be us finding discrepancies in the few days that we are there. That is your job. They are not that hard to find. Why are you not finding these issues in your internal audits?
I would like you to take a look at your company’s quality culture.

Is your quality system on the immature or mature side of the quality system? Are you reacting to problems or are you proactively looking for gaps and deficiencies to correct those before they become big problems?
Also of note—if you are interested in learning more about observations filtered by FDA issue/Keyword “Aseptic Processing”, get your FREE 483 Observation Report and quickly determine who has been hit with this observation and more. Learn more here.